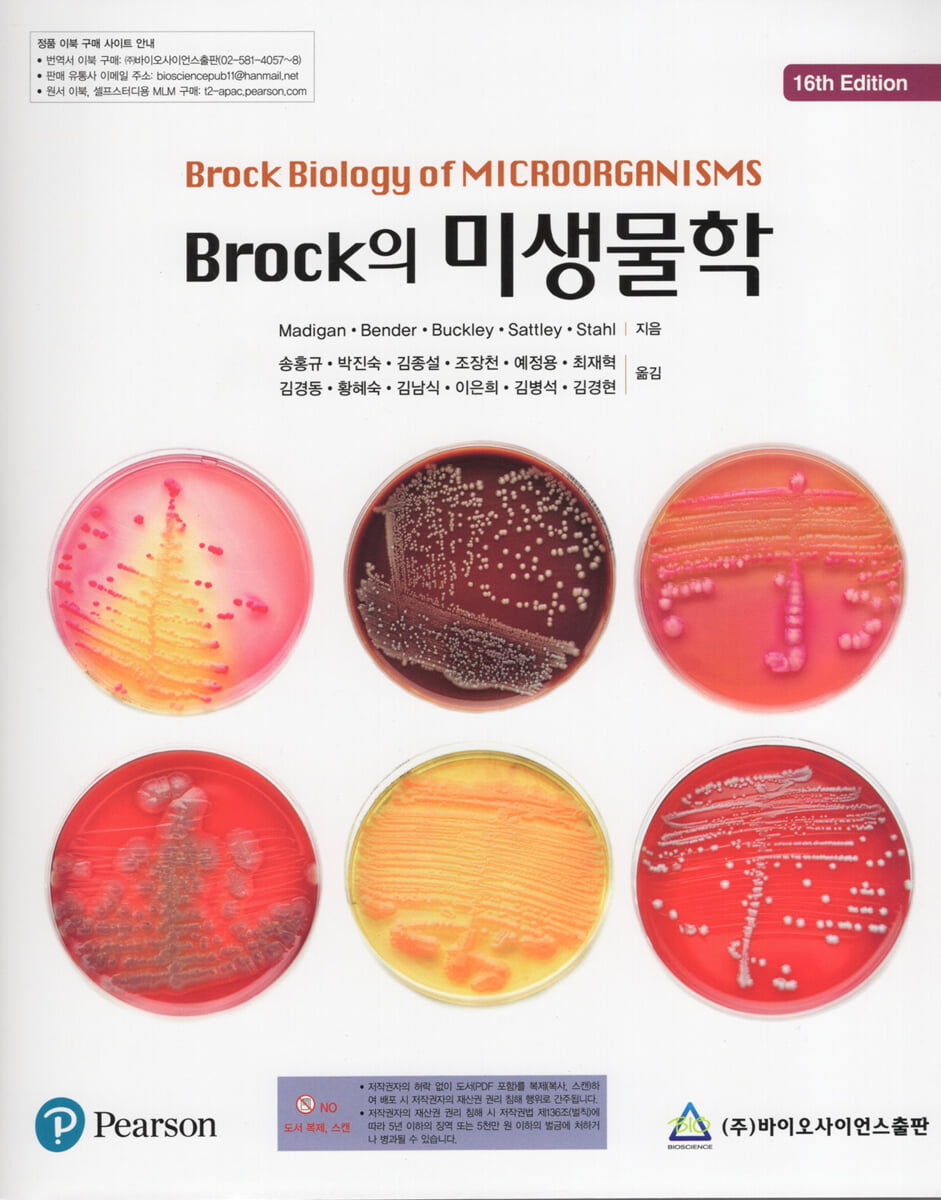

Microbiologie de Brock
|
SPÉCIFICATIONS DES PRODUITS
- Date de publication : 5 mars 2020
Nombre de pages, poids, dimensions : 1 068 pages | 224 × 274 × 60 mm
- ISBN13 : 9789813351639
- ISBN10 : 9813351632
Vous aimerez peut-être aussi
카테고리
Langue coréenne


Langue coréenne


![GQ KOREA Mark (Mensuel) : décembre [2025]](http://librairie.coreenne.fr/cdn/shop/files/8ef265dbbfbf186523ed75ba7319009d.jpg?v=1765340328&width=3840)























